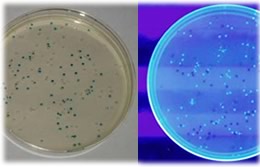

可以安全簡單地學習基因改造操作。
(對象:高中・專科・大學基礎)
特徵
- 不使用特別試劑。
- 不需要特別的設備材料。
- 不需要事先進行麻煩的準備工作。
- 附帶滅菌袋,廢棄很簡單。
- 可以安全簡單地學習基因改造操作。
- 使用無病原性的安全大腸菌( E.coli K-12株)。
- 可以學習基因發現調整結構。
- 使用IPTG與X-gal學習發現和調整LacZ基因。
- 可以目視實驗結果。
- 導入基因採用螢光蛋白(GFP)基因與β-半乳糖苷酶(LacZ)基因、耐藥性(氨苄青黴素耐藥性)基因3種。
- 質體採用2種。(GFP與氨苄青黴素耐藥性、LacZ與氨苄青黴素耐藥性)
- 不需要特別的設備材料。
- 需要恒溫槽和細菌培養器、UV燈等。
- 不需要事先進行麻煩的準備工作。
- 老師的事先準備工作較少,因此可事先製作培養盤等。
- 附帶滅菌袋,廢棄很簡單。
- 使用完的培養盤等可以匯總放到滅菌袋中,滅菌後作為普通垃圾丟棄。
(部分自治體會有不同規定,請注意確認。)
- 使用完的培養盤等可以匯總放到滅菌袋中,滅菌後作為普通垃圾丟棄。
關於導入基因
質體
大腸菌內除了本身的DNA染色體組外,還有名為質體的環狀DNA。這種質體內含有具備普通功能的基因,大腸菌透過共用這種質體,進而獲得應對各種環境的性狀。
本實驗裝備利用這一特性,同時將事先混有螢光蛋白質(GFP)和半乳糖苷酶(LacZ)基因的2種質體(pBR322)導入到大腸菌內,分別進行性狀轉換。此外,還分別在相同質體上導入耐藥性基因(氨苄青黴素耐藥性基因)作為選擇標誌物。







